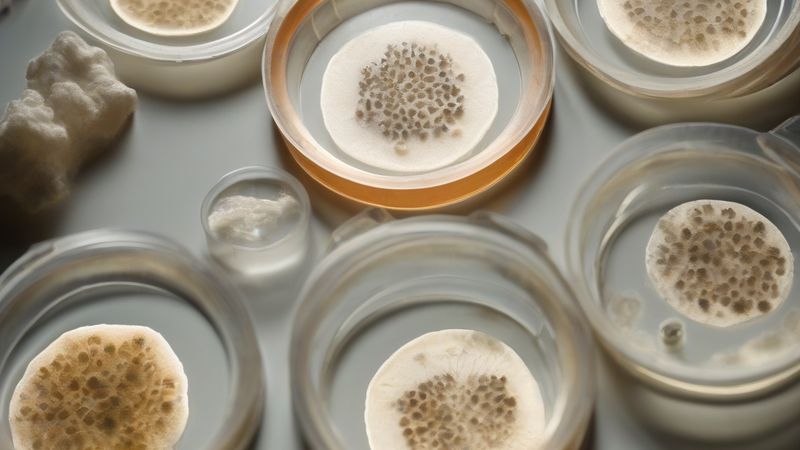

Розумні рішення
Дослідники виявили, як штучний інтелект може зробити суспільство менш егоїстичним. Експеримент показав, що певні форми штучного інтелекту можуть сприяти розвитку співпраці між людьми.
Наукові відкриття, космос, природа, технології майбутнього

Дослідники виявили, як штучний інтелект може зробити суспільство менш егоїстичним. Експеримент показав, що певні форми штучного інтелекту можуть сприяти розвитку співпраці між людьми.

Університет Комплутенсе в Мадриді відкрив новий музей психології, де представлені численні експонати, що демонструють історію та розвиток психологічної науки. Музей містить колекцію інструментів та артефактів, які раніше належали відомим психологам та науковцям.

Астронавт Майк Фінке розповів про свою хворобу, яка стала причиною першої медичної евакуації у космосі. Ця подія відбулася на Міжнародній космічній станції.

Вчені розкрили секрет кричання кросівок під час руху, що може мати велике значення для інженерії та фізики. Дослідження показало, що цей звук пов'язаний з динамікою матеріалів.

У Патагонії виявили динозавра вагою одного кілограма. Це відкриття говорить про різноманітність життя на Землі.

Учені виявили хімічні речовини з електронних відходів у дельфінів і марсопах. Це відкриття спричинило занепокоєння щодо впливу технологій на довкілля.

Астронавт Майк Фінкек став першим астронавтом, якого евакуювали з космосу через медичні причини. Фінкек розповів про свій досвід у заяві, опублікованій НАСА.

Ученні відкритили динозавр-мініатюрку в Патагоні, який став ключем до розуміння еволюції цих створінь. Динозавр-мініатюрка Alnashetri cerropoliciensis мав розмір лише 1 кг і був одним з найменших динозаврів у світі.

Учені виявили новий вид динозавра, який був розміром з курку та належав до групи тероподів. Це відкриття змусило вчених переглянути свою теорію про еволюцію динозаврів.

На галапагоському острові Флореана вдруг повернулися тортуги-гіганти, яких вважали вимерлими понад 150 років. Це стало можливим завдяки програмі відновлення екосистеми острова.

У лago італійському озері Браччано виявлено колекцію неолітичних луків, які свідчать про те, що сільське господарство і полювання співіснували у ранньому неоліті. Ця знахідка дає нове уявлення про життя перших сільськогосподарських громад у Західному Середземномор'ї.

У будинку Манхеттена 1832 року знайдено таємний пасаж, який, як вважають, був частиною підземної залізниці для рабів. Ця знахідка змусила істориків переглянути минуле Нью-Йорка.

Дослідження показало, що лише 0,1% вчених відкрито зізнаються в використанні штучного інтелекту при написанні статей, попри широке поширення цієї технології. Це ставить під сумнів ефективність чинних правил прозорості в наукових публікаціях.

У 1949 році американські вчені випадково записали пісню кита, яка тепер вважається найстарішим збереженим записом пісні кита у світі. Цей запис був знайдений у архіві в Масачусетсі.
Ученi вiдкрили генетичнi механізми, які дозволяють грибам адаптуватися до інфекції людини. Цей відкриття може привести до розробки нових лікарських засобів проти грибкових інфекцій.

У Польщі було виявлено римську труну, яка простояла майже 2000 років, і її дослідження викрило похибку у методі визначення віку артефактів за допомогою радіовуглецю-14. Цей випадок став прикладом того, чому науковці повинні перевіряти результати та використовувати різноманітні методи для визначення віку історичних знахідок.

Дослідники виявили, що шимпанзе споживають алкоголь у вигляді ферментованого фрукту, а рівні алкоголю в їхній сечі відповідають одному-двом чаркам на день. Це відкриття було зроблено вченим Алєксеєм Маро з Університету Каліфорнії у Берклі.

Нові дослідження пропонують, що рибосома, ключова частина клітин, могла виникнути як молекулярний паразит понад 3,5 мільярдів років тому. Ця гіпотеза повністю змінює наше розуміння походження життя.

Учені відкрили генетичну мутацію, яка зменшує паління, що може стати новим напрямком у лікуванні нікотинової залежності. Ця мутація впливає на ген CHRNB3, який кодує білок, що бере участь у процесі дії нікотину на мозок.

Ватиканська бібліотека повернула рідкісний манускрипт XVI століття, який вважався втраченим понад 200 років. Цей манускрипт має велике історичне та текстове значення.

Учені змогли відтворити рецепт стародавньої грецької напою kykeon, який міг містити психоактивні речовини. Це відкриття може пролити світло на одну з найбільших загадок стародавньої Греції.

Чому важливо розрізняти інформацію та дезінформцію в мережі? Як можна зробити цього?

Вчені створили пристрої з гвинтовою геометрією, які можуть контролювати проходження електричного струму. Це відкриває нові можливості для розробки пристроїв майбутнього.

Рекордні спеки можуть заперечити проведення Тур де Франс улітку. Жарка погода ставить під загрозу здоров'я велогонщиків.